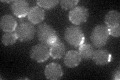
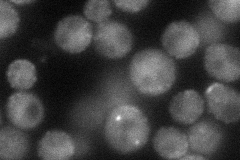
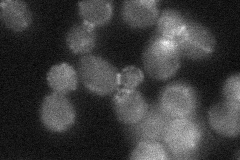
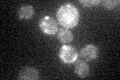

View description
Alpha-adaptin, large subunit of the clathrin associated protein complex (AP-2); involved in vesicle mediated transport
Localization:
Intensity:
Fold change:
Significance:
-
C’ GFP library in SD
cell periphery, bud neck -
N' NOP1pr-GFP in SD
punctate,bud neck60.1415 -
N' TEF2pr-mCherry in SD

punctate,bud neck32.4077 -
N' NATIVEpr-GFP in SD
bud neck26.4632 -
N' TEF2pr-VC and Cyto-VN in SD

below threshold28.769 -
C’ GFP library in SD+DTT

cell periphery, bud neck28.430.97No -
C’ GFP library in SD+H2O2

cell periphery, bud neck30.971.05No -
C’ GFP library in Starvation Media
punctateN/AN/AYes -
C’ GFP library on the background of Pup2-DaMP

cell periphery, bud neck -
C’ GFP library on the background of CCT mutant

cell periphery, bud neck26.75770.912722No
